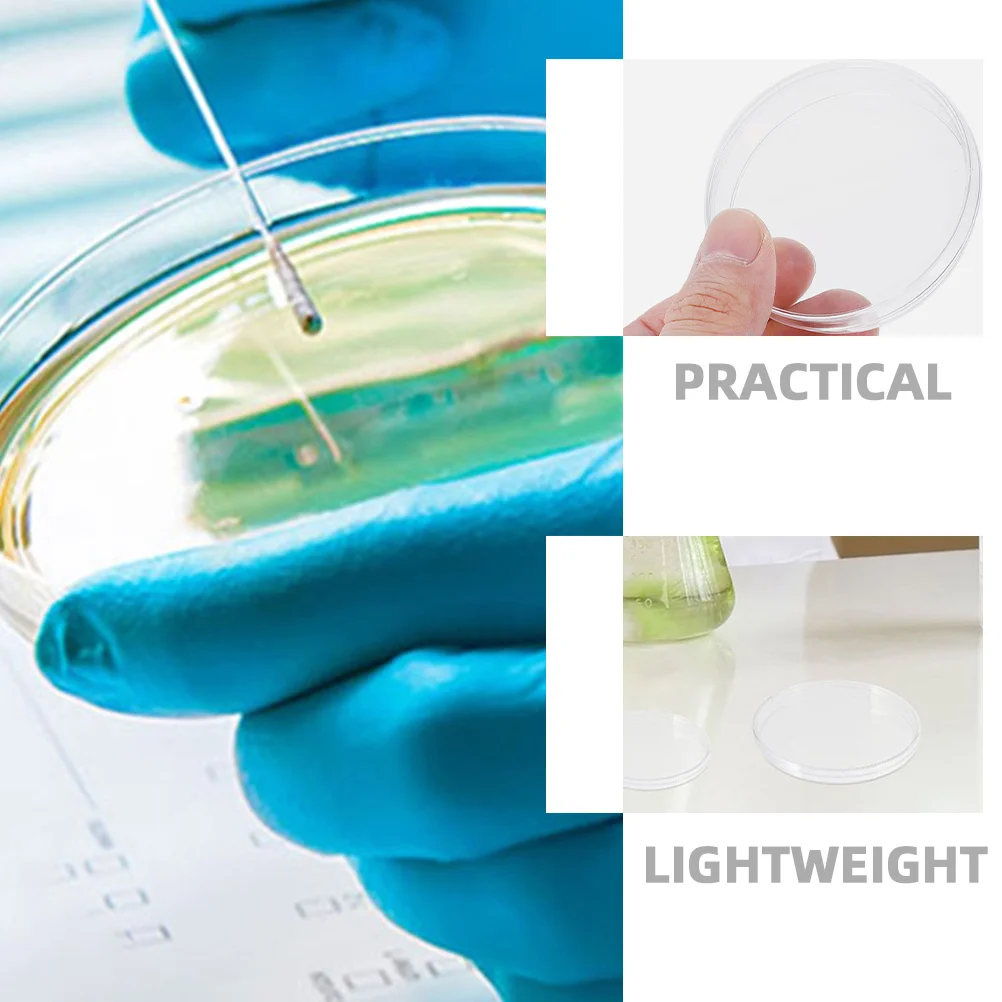
20Pcs Petri Dishes Clear Laboratory Culture Plates Lids Agar Plates Protective for Chemistry Research Petri Dish

Кольцо серебряное с золотыми вставками "Шалфей" Синий, 17

артикул: 689596225
СОГЛАСНО НАШИМ ДАННЫМ, ЭТОТ ПРОДУКТ СЕЙЧАС НЕ ДОСТУПЕН
547.00 грн.
Доставка из: Украина
График изменения цены & курс обмена валют
Пользователи также просматривали

155.53 грн.
Donut Make Maker Cake Baking Mould Impression Mould Press Mould Bagel Maker Donut Baking Tools Baking Moulds
aliexpress.com
16,066.74 грн.
Прямая продажа с фабрики 50 мм F1.1 Большая диафрагма объектив с ручной фокусировкой стандартный объектив для камеры Leica M
aliexpress.ru
4,878.44 грн.
Подсветка для каретки подходит для HP Designjet T1200 T2300 T790 T1100 T770 T1300
aliexpress.ru
1,087.05 грн.
Portable Tube PU 2/3 Slots Cigar Box Case Easy Carrying Travel Accessories Leather Humidor with Cigar Cutter Gift
aliexpress.com
401.69 грн.
Clear Champagne Flutes Glass Retro Decor Shot Glasses Martini Coffee Mugs red Wine Glass tea Cup home Mimosa Bar Party Supplies
aliexpress.ru
4,580.86 грн.
zqEuropean-Style Living Room Ceramics Wine Cabinet Floor Large Vase Creative Porcelain Large Roman Column Flowerpot
aliexpress.com
7,087.10 грн.
New Feather Fabric French Mesh Lace French Lace Fabrics Quality 2023 Feather Fabric Beaded Lace Fabric For Party 5 Yards KB3446
aliexpress.com
2,565.67 грн.
2023 Women elegant Red Off Shoulder one-piece luxury Evening Holiday prom Cocktail gala party Ostrich Feather Jumpsuit
aliexpress.com
282.41 грн.
Trophy Decoration Small Piano Plastic Trophies Singing Competition Awards Delicate Musical Note
aliexpress.com
104.95 грн.
20pcs 1mm Diamond Coated /Lapidary Drill Bits Silver Solid Bits/ Needle For Jewelry Agate Jade Agate Stone Crystal Ceramic Glass
aliexpress.com
4,712.79 грн.
Motorcycle Real Carbon Fiber Rear Upper Center Seat Cover Tail Light Fairing For HONDA CBR1000RR-R CBR 1000RRR 2021 2022 2023
aliexpress.com
21,276.06 грн.
FOR DIESEL ENGINE AGRICULTURAL MACHINERY CAR TRUCK DIAGNOSTIC SCANNER TOOL DIAGNOSTIC SCANNER FOR YANMAR OBD2 AUTO SCAN TOOL
aliexpress.com
40.04 грн.
1Set For 2pin EV6 USCAR Auto Fuel Line Quick Injector Connector Plug Socket 15419715 15423278 15423276 0090-013
aliexpress.com
703.06 грн.
Girls Summer Short Sleeve Striped Baseball Jacket Denim Shorts Cotton T Shirt Kids Streetwear Clothes Children Hip Hop Costume
aliexpress.com
1,715.08 грн.
Полюсный Зажим с компасом и держателем для телефона, подставка для GPS, для Trimble TOPOCN, общая станция сбора данных
aliexpress.ru
10,116.00 грн.
Hybrid Solar Inverter 24V 3KW Pure Sine Wave Inverter Off Grid Build in 80A MPPT Charger 220v Max PV 450V
aliexpress.ru
1,146.06 грн.
Сенсорный ридер открытая Луна Звезда комната Декор для дома Новогодняя стена Свадьба 2 цветной дисплей светодиодная неоновая вывеска
aliexpress.ru
69.55 грн.
Ремешок силиконовый для Xiaomi Mi Band 3 4 5 6, модный спортивный сменный Браслет для наручных часов с рисунком, аксессуары для часов
aliexpress.ru
410.12 грн.
Садовые статуи животных на солнечной батарее, уличные садовые фигурки, олень, кролик, ежик, волк, украшение из смолы
aliexpress.ru
42.15 грн.
1 заточка направляющая Дрель адаптер пилы, Заточной крепления для вращающихся Мощность Инструменты Мини-дрель аксессуары
aliexpress.ru
7,519.00 грн.
Гидроаккумулятор c фиксированной мембраной 105 л ZILMET HYDRO-pro 10bar ( 11A0010500 )
allo.ua
2,931.95 грн.
ZC brass sailing desk ornament handicrafts home wine cabinet decoration office creative decoration
aliexpress.com
67.44 грн.
20Pcs Petri Dishes Clear Laboratory Culture Plates Lids Agar Plates Protective for Chemistry Research Petri Dish
aliexpress.ru











